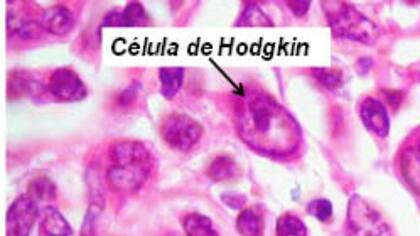

La lucha de Pilar para enfrentar la enfermedad de linfoma de Hodgkin
Estudiante de 23 años, debió afrontar un cáncer hematológico y va por su tercer tratamiento en cuatro años; las nuevas terapias
 1 minuto de lectura'
1 minuto de lectura'


Apenas salida del secundario, Pilar Galassi, una joven estudiante de la ciudad bonaerense de Lobería, ya tenía decidido que iba a ser contadora pública.
Toda su voluntad, empeño y alegría estaba puestos en esa meta. Pero al año siguiente, en 2012, comenzó a sentir fuertes dolores de espalda que aparecían y desaparecían sin ninguna explicación.
Tras ello, experimentó episodios de fiebre alta, sudoración nocturna y fuertes dolores de hígado que no eran comunes, dada su sana alimentación. Después de una internación con tomografías y biopsias incluidas, fue diagnosticada con linfoma de Hodgkin, un cáncer que se origina en los glóbulos blancos, llamados linfocitos (parte del sistema inmunológico del cuerpo humano), que comienzan a crecer en forma descontrolada con la posibilidad extenderse a varias áreas del cuerpo.
“Yo tenía linfoma ubicado en el mediastino (pecho), el bazo y parte del cuello”, contó Pilar a LA NACION en una comunicación telefónica. A partir de allí comenzó un calvario que todavía no tiene una solución definitiva, pero gracias al apoyo de familiares y amigos, puede hacerle frente a esta enfermedad.
En el Día Mundial del Linfoma, el testimonio de Pilar busca concientizar a la población de la importancia de un diagnóstico precoz para detener una enfermedad que, en poco tiempo, puede diseminarse en el cuerpo.
Cada 90 segundos se diagnostica a una persona con linfoma en el mundo, una enfermedad que produce 200.000 muertes al año. En la Argentina sólo el 20 por ciento de los diagnosticados sabe de la enfermedad.
“La problemática es compleja. Por un lado, la población desconoce la existencia y los síntomas de esta enfermedad y por el otro, no hay estadísticas oficiales de la cantidad de afectados en nuestro país”, aseguró la doctora Virginia Prates, que además de ser la médica cabecera de Pilar, es coordinadora de Oncohematología y subjefa de la Unidad de Trasplante de Médula del Hospital Italiano de La Plata.
Según explica la experta, los linfomas son un tipo de neoplasia (masa anormal) hematológica que se manifiesta en órganos del sistema linfático. Junto con la leucemia y el mieloma representan la quinta causa de muerte por cáncer en el mundo.
Existen fundamentalmente dos grandes categorías de linfomas: linfoma de Hodgkin y linfoma no-Hodgkin (LNH), la forma más frecuente que afecta a cuatro de cada cinco pacientes con esta enfermedad.
Síntomas
Sin duda, conocer los síntomas colabora con la detección temprana de la enfermedad. Según explica Haydée Gonzalez, presidenta de Linfomas Argentina, una asociación civil sin fines de lucro de pacientes y familiares de pacientes con linfoma, mielodisplasia y mielofibrosis, el aumento de tamaño de un ganglio o grupo ganglionar que no corresponde a una infección es el primero de los síntomas visibles.

“Los lugares más comunes donde pueden detectarse estos ganglios son la axila, la ingle y el cuello. Además, se experimenta sudoración nocturna, tos o disnea, mucho cansancio, pérdida de peso y en algunos casos prurito o picazón en todo el cuerpo”, explicó a LA NACION.
Algunos de esos síntomas fue los que sintió Pilar. “Hoy estoy atravesando mi tercer tratamiento. El primero fue en Tandil, donde estuvo internada mi mamá que atravesó por un cáncer de mama. Después, en 2014, afronté mi segundo tratamiento en el Hospital Italiano, de La Plata. Allí me realizaron tres quimioterapias y un autotrasplante de células de la médula ósea”, comentó la joven.
Pero remarcó: “Lo más frustrante es que la enfermedad desaparece, pero vuelve a aparecer. Ahora tuve tres quimioterapias más y voy por un posible trasplante de médula con uno de mis hermanos”.
Desde la asociación civil Linfomas Argentina se trabaja todos los días para lograr que la enfermedad y sus síntomas tenga mayor difusión a fin de poder colaborar con un diagnóstico temprano para tener un pronóstico más favorable, según explica su presidenta. De acuerdo a las investigaciones los pacientes que se detectan en un estadio temprano tienen 70% de probabilidad de supervivencia a 5 años, en comparación con 58% de los pacientes en estadío avanzado.
Afortunadamente, en materia de control de la enfermedad en las últimas décadas se han producido grandes avances gracias al mejor entendimiento de la fisiopatología de los linfomas. De la mano de la biotecnología, estos hallazgos permitieron desarrollar terapias dirigidas que atacan selectivamente a las células tumorales y otras que interfieren en el mecanismo de desarrollo de la enfermedad.
“Somos testigos de un cambio rotundo en los tratamientos con drogas de blanco molecular que no sólo tienen mejores resultados sino que no tienen ninguno de los efectos adversos de la quimioterapia. Probablemente en un futuro cercano tengamos disponibles novedosos tratamientos con mínimas complicaciones que además de curar a más pacientes les ocasionen menos complicaciones relacionadas al tratamiento”, precisó la doctora Prates.
Nuevo tratamiento contra el linfoma de Hodgkin
El linfoma de Hodgkin es el primero en incidencia en jóvenes y con un 90% de posibilidades de cura con un diagnóstico precoz. En la Argentina cada año son diagnosticadas con linfoma de Hodgkin aproximadamente 1000 personas y casi 345 con el linfoma anaplásico de células grandes (LACGs).
Para ambas enfermedades, está disponible en el país un nuevo tratamiento de vanguardia, indicado para pacientes cuya enfermedad ha regresado luego de varios tratamientos, incluyendo el trasplante autónomo de células progenitoras, o para aquellos que no pueden someterse a un trasplante. Se trata del primer tratamiento en más de 20 años que mejora significativamente las posibilidades de supervivencia.
En el marco de la 1° Jornada Latinoamericana de la Sociedad Argentina de Hematología (SAH), el profesor Martín Hutchings presentó la terapia anti CD30, una nueva alternativa de tratamiento para los pacientes con Linfoma de Hodgkin.
El ensayo clínico que llevó a la aprobación de Brentuximab vedotin fue un estudio de fase II efectuado en 102 pacientes con linfoma de Hodgkin en recaída o refractario. “La efectividad fue impresionante, con un 75% de los pacientes respondiendo al tratamiento y muchos de ellos con respuestas de larga duración”, destacó Hutchings.
“Desde hace tiempo se necesitan nuevas terapias que den resultados efectivos frente a las recaídas de los pacientes con esta enfermedad”, sostuvo la doctora Marta Zerga, presidenta de la Sociedad Argentina de Hematología (SAH) y directora del área Clínica del Instituto de Oncología Ángel Roffo de la Universidad de Buenos Aires.
Esta nueva terapia también podría ayudar a Pilar, que se aferra a la vida cada vez que piensa en su enfermedad: “Tengo que estar enfocada en esto. En superar este problema, para volver a dedicarme a hacer otras cosas, como volver a estudiar lo que me gusta”.
Actividades
Linfomas Argentina celebra el Día Mundial del Concientización sobre Linfomas con actividades en todo el país. Voluntarios estarán presentes en distintos puntos del país para acercar a la comunidad su mensaje de concientización.
En Buenos Aires, se repartirán volantes en el Obelisco a partir de las 11 hs y a las 17 hs será el cierre de campaña en el Salón Montevideo de la Legislatura de la Ciudad de Buenos Aires.
Para conocer más sobre Linfomas Argentina: http://www.linfomasargentina.org/home.php o comuníquese vía telefónica al 0800-5555-4636 o por mail a info@linfomasargentina.org . También puede visitar sus redes sociales. En Facebook /AsociaciónLinfomasArgentina o en twitter @linfomasAr





